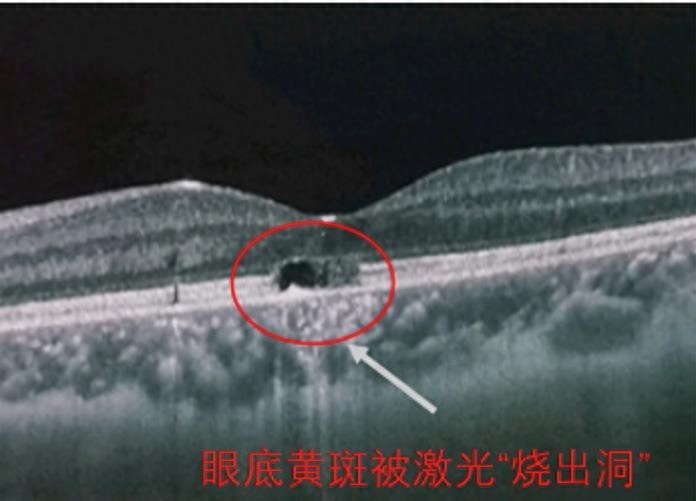

激光笔看着轻巧方便,使用不当可能成为伤眼“凶器”。日前,惠安8岁男童兵兵(化名)在和同学玩耍时,被一款网红“逗猫激光笔”直射眼睛配资炒股流程,仅照射几秒钟,导致他视力严重受损,视物模糊,视力从1.0的正常水平骤降至0.2。医生提醒,激光笔不仅会损伤视网膜,还可能导致视网膜穿孔、黄斑损伤甚至黄斑穿孔等不可逆的视力损伤。
(医院供图)
“逗猫激光笔”直射眼睛
男童视力骤降至0.2
8岁的兵兵近期在学校体检时,被查出视力明显异常,家人带他到泉州市妇幼保健院(泉州市儿童医院)就诊,经眼科医学中心刘杏主治医师检查,兵兵只能看到视力表前3到4排大视标,眼部中央有遮挡感,视物模糊,检测后视力只有0.2,被确诊为“双眼激光性黄斑损伤”。
医生询问病史后得知,不久前,兵兵在玩耍时,被同学带来的“逗猫激光笔”直射眼睛。没想到只是短暂地被照射几秒,他的视力就从正常水平骤降至0.2。他的视网膜上负责感光的细胞层已出现中断与缺失。
刘医生介绍,黄斑是眼睛视物最清晰的核心区域,一旦受损,可能出现眼前暗点、视物模糊,严重时甚至会导致视力急剧下降。如出现新生血管,可能导致视力下降明显、视物变形。
庆幸的是,兵兵眼底暂未出现新生血管。经过抗炎联合卵磷脂营养眼底支持等治疗,一个半月后,兵兵的视力逐渐恢复到了0.7。
而石狮6岁女童妍妍(化名)就没那么幸运了。她一时好奇偷玩爷爷出海用的激光笔,激光光束直射眼睛,导致一眼黄斑出血,视物模糊,几近失明,通过治疗仍无法完全恢复视功能,视力已出现不可逆损伤。
直射可瞬间灼伤眼睛
严重引发视网膜穿孔
记者在电商平台搜索“逗猫激光笔”,发现其价格从几元到几十元不等,销量可观。记者咨询客服“是否可以给孩子玩”时,客服提醒:激光笔不可以对着眼睛照射,孩子在使用时,需要大人在一旁看护。
小小一支激光笔,对眼睛为何有这么大破坏力?刘医生介绍,市面上多数激光笔,尤其是“高亮”“远射”款式,功率远超安全标准。当激光直射眼睛时,视网膜会快速吸收能量并转化为热能,就像放大镜聚光烧纸一样,瞬间灼伤脆弱的视网膜,尤其容易损伤黄斑区域。轻度损伤会导致视物时出现黑影,严重时则可能引发黄斑裂孔、视网膜穿孔,给孩子造成终身视力问题。
此前苏州消防曾做过一组实验:用激光笔对准火柴头照射仅2秒,火柴便被引燃;照射报纸10秒,纸张直接被烧穿;持续照射猪皮5分钟,就能烧出直径约5毫米的黑洞。这意味着,激光笔不仅会伤眼,还可能点燃易燃物引发火灾,直接接触皮肤也会造成烧伤。
浴霸强光也别直视
假期注意防范眼外伤
刘医生介绍,要避免激光笔的危害,家长要教导孩子,别把激光笔当玩具,不能对着人,尤其是眼睛照射。家中有用激光笔,要收纳在孩子够不到的地方防止误用。
除了激光笔,冬季不少家庭会在洗澡时开浴霸,这种光线对幼儿来说,使用不当眼睛容易受伤。一旦发现孩子出现视力骤降、视物变形或眼前有固定黑影等症状,应尽快到医院眼科就诊,避免因延误治疗造成不可逆的视力损伤。
“寒假来临,儿童好奇心又强,一不留神就容易发生意外,引发眼部外伤的病例增多。”刘医生介绍,近期接诊病例中,有孩子吃烧烤时把握不好力度被竹签刺穿角膜,还有的幼儿在嬉闹时磕到桌角导致眼外伤。
她提醒,家长对幼儿要做好看护,对于剪刀、刀片、竹签、螺丝刀等尖锐物品要妥善保管。春节期间燃放烟花爆竹,孩子要有成人陪同,保持安全距离,避免炸伤。
一旦发生眼部外伤,切勿自行按压、揉搓眼睛,也不要随意涂抹药膏,应立即用干净纱布或毛巾轻轻遮盖眼部,并尽快就医。
来源:东南早报配资炒股流程
钱龙配资提示:文章来自网络,不代表本站观点。